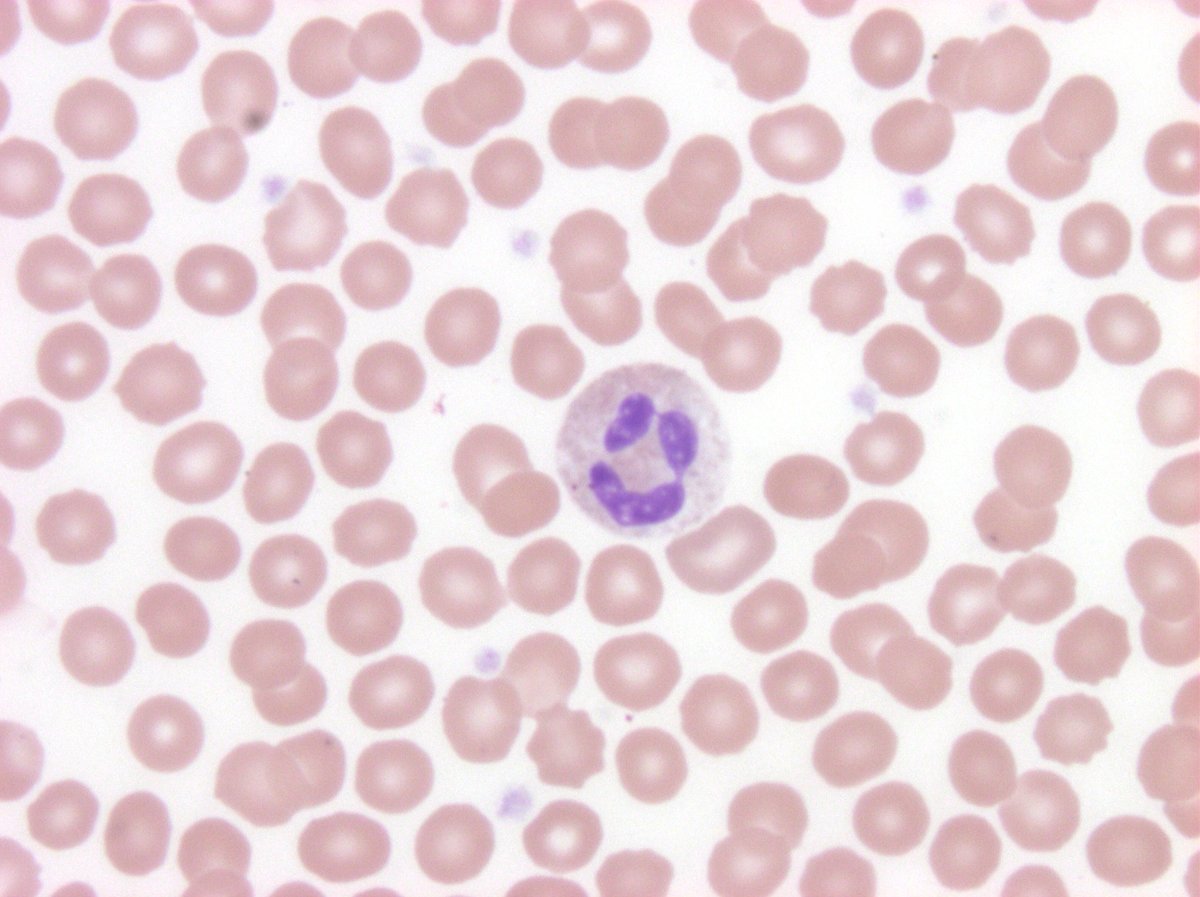
#hemepath Have a nice...whatever
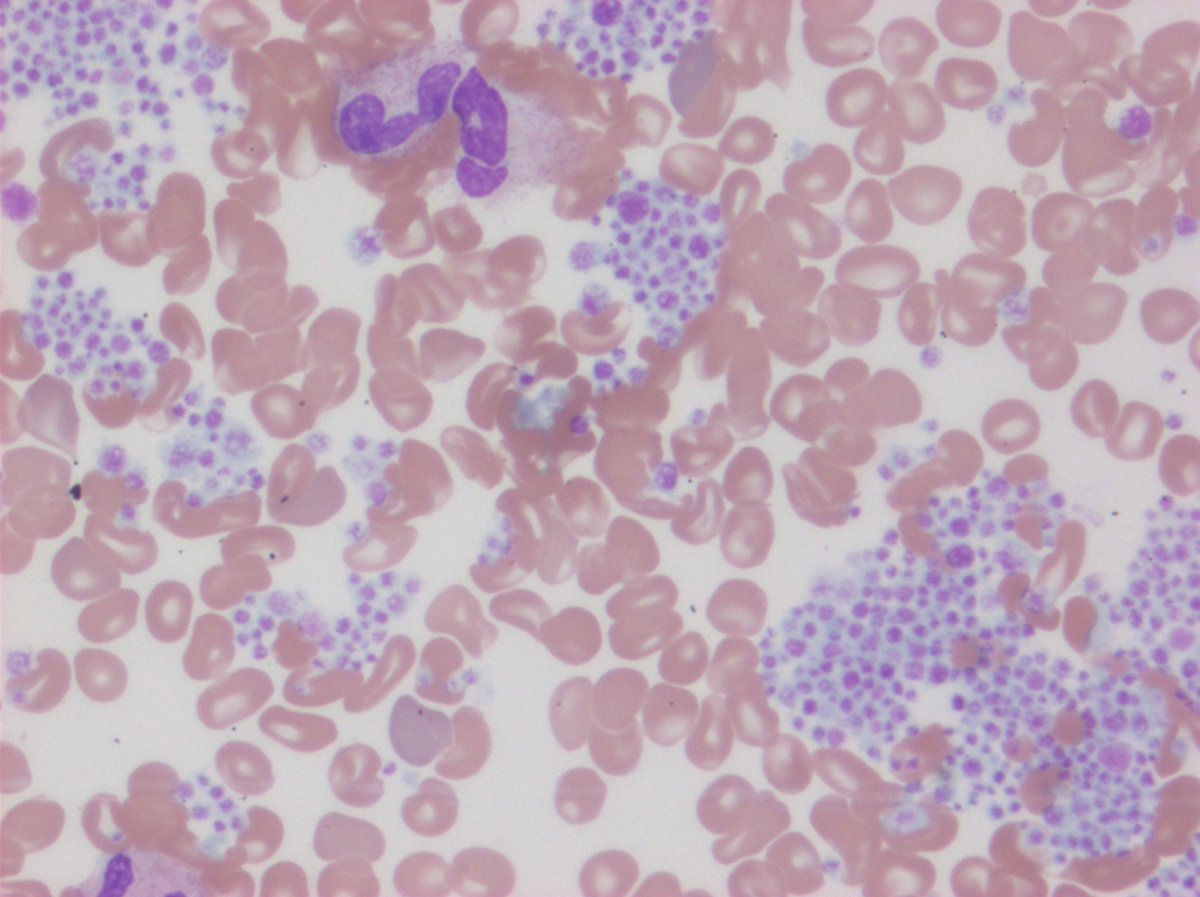
Hey - why is the platelet count "unreportable"? Oh, now I see -&gt; Peripheral blood smear near edge
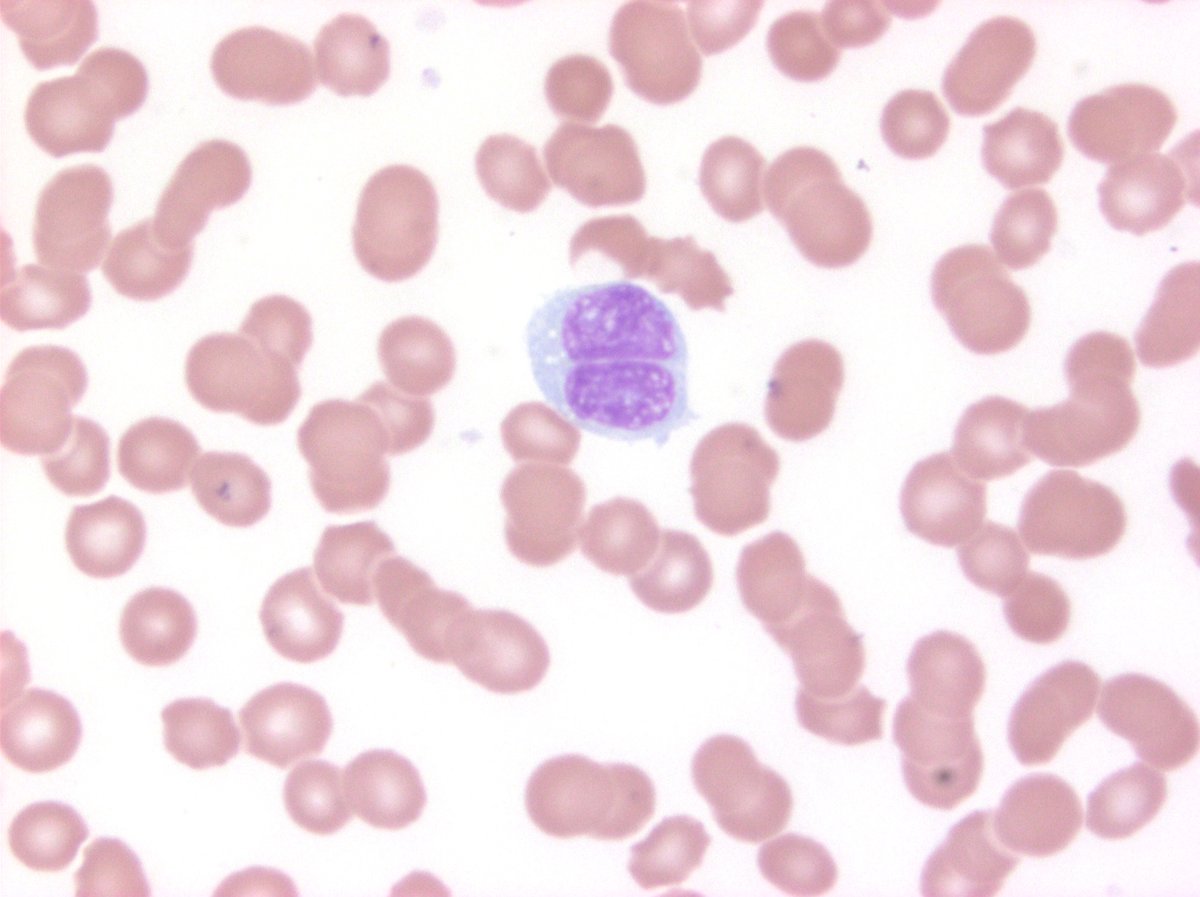
Some shots of hairy cell leukemia-variant, from my colleague Ants. CD103+, CD11c+; negative CD25. No BRAF. Positive TP53 mutation #hemepath
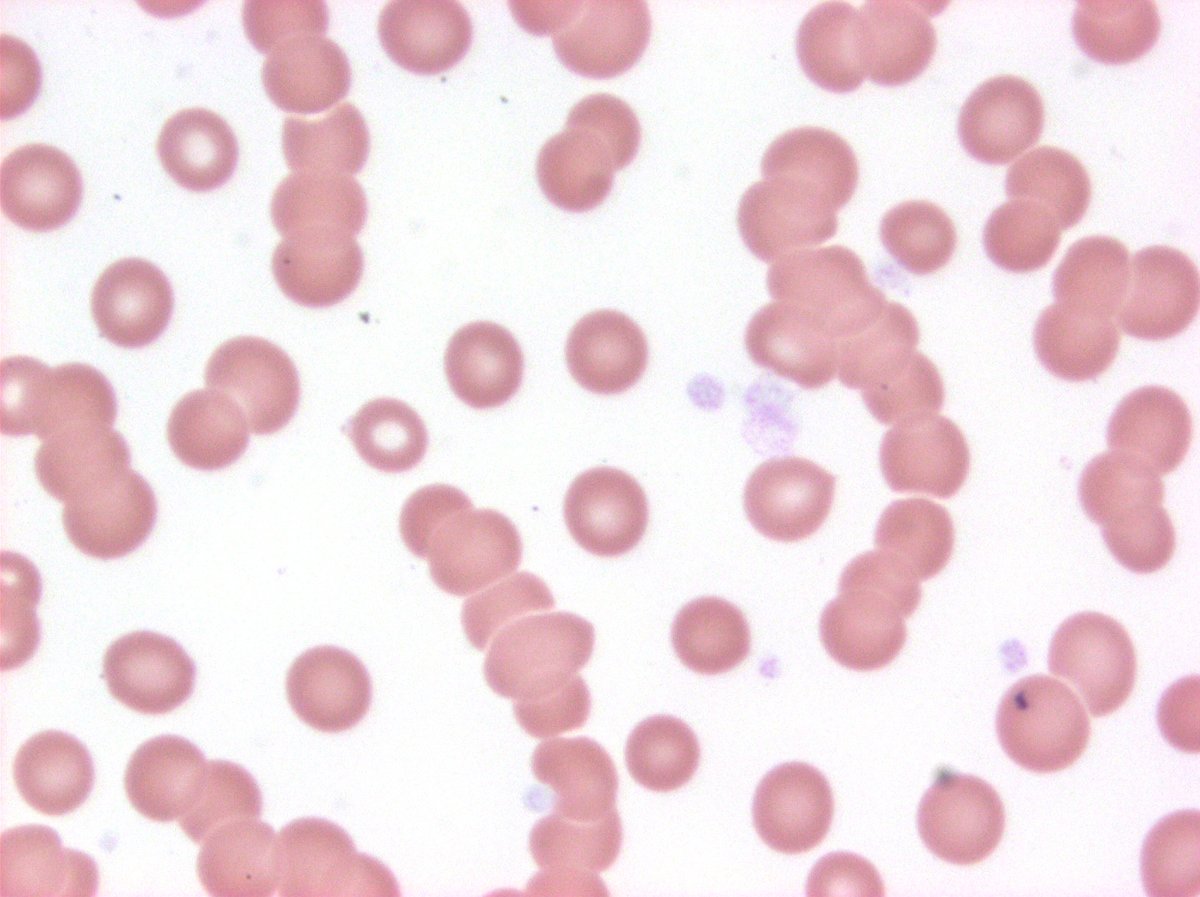
Just a nice pic of rouleaux associated with plasma cell myeloma
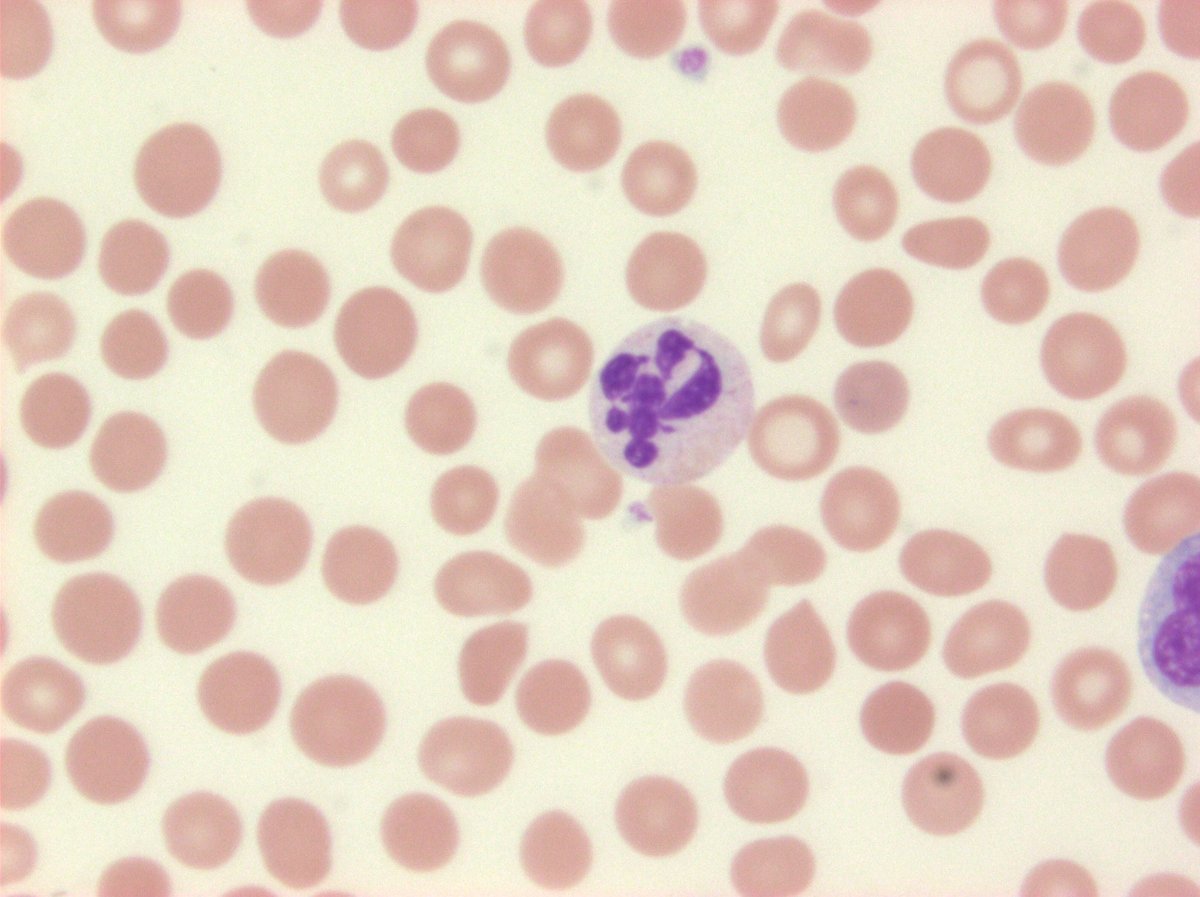
Funny looking neutrophil from CMML. Kinda like Prince's symbol combined with a scorpion?
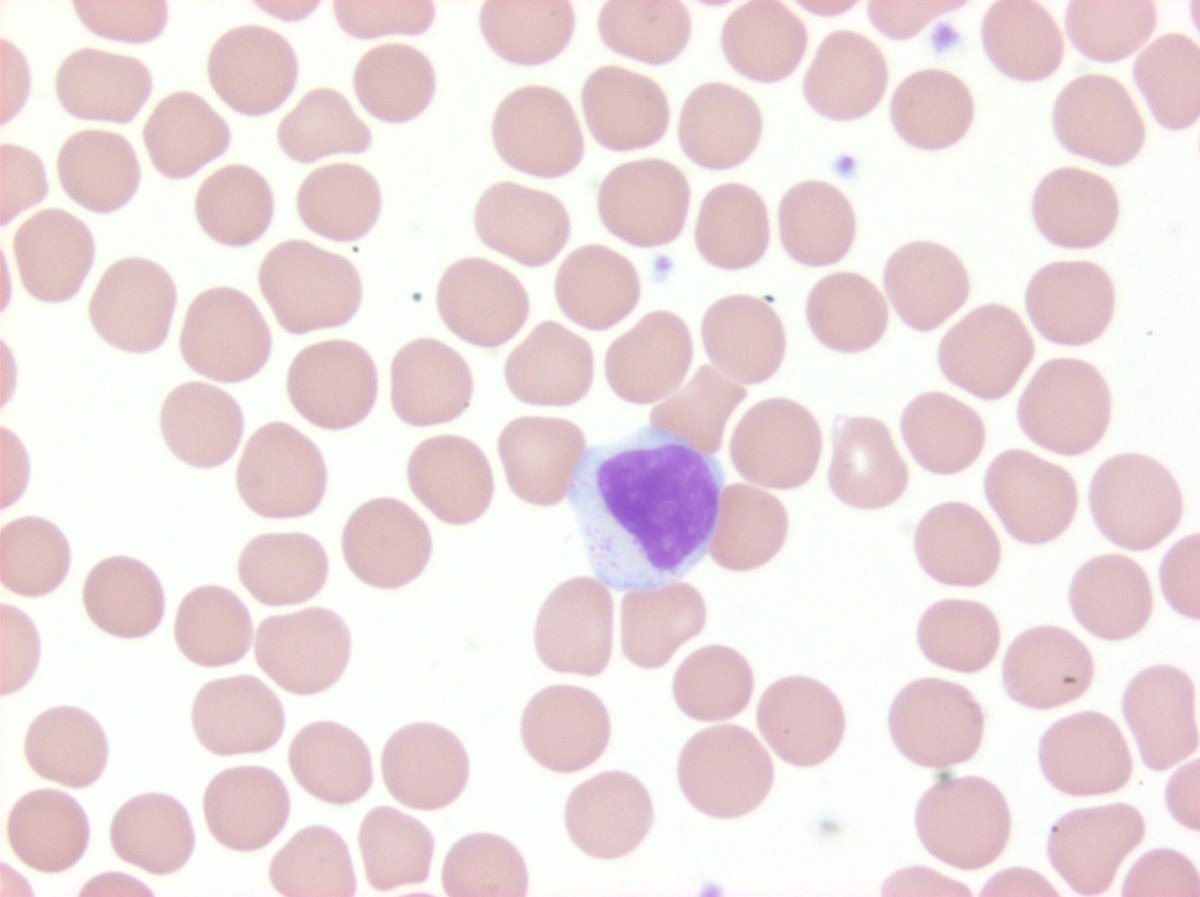
T-LGL, clonal, but not quite high enough counts to make T-LGL leukemia

Dennis P. O'Malley, MD
@dennisomalleymd
Hematopathologist @NeoGenomics, Adjunct Associate Professor at MD Anderson Cancer Center/University of Texas.
ID: 963141039224573952
12-02-2018 20:01:32
1,1K Tweet
2,2K Takipçi
115 Takip Edilen










Just a reminder to anyone who follows me. I will be retiring my Dennis P. O'Malley, MD twitter handle and will be reborn as @Hemepathguy as of June 30/July 1







Just a reminder this twitter handle is going dark - please follow me at @Hemepathguy - thanks Dennis O'Malley, MD